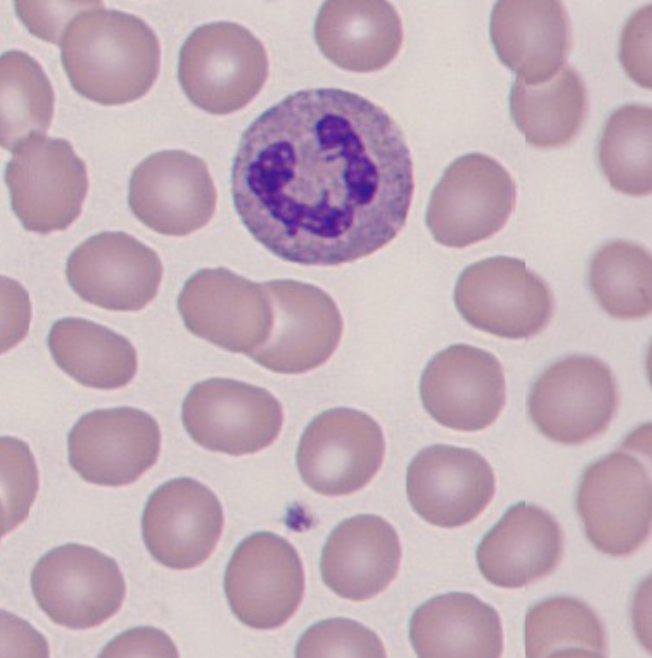
knowt flashcard image
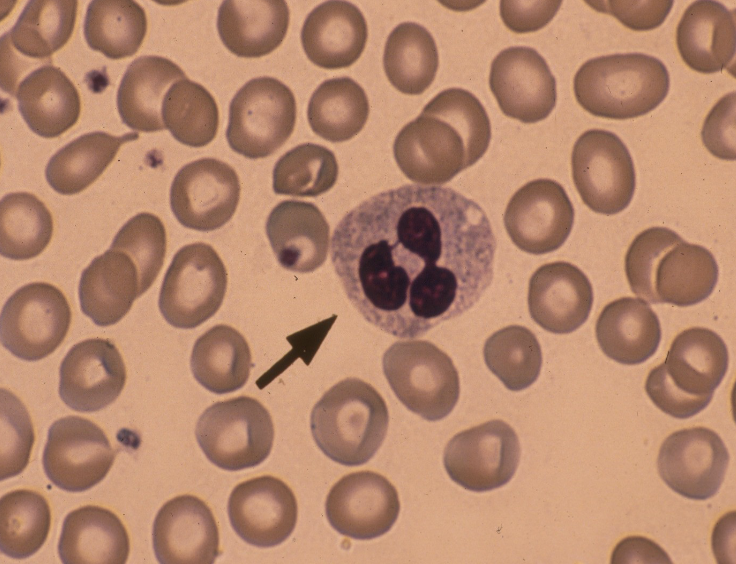
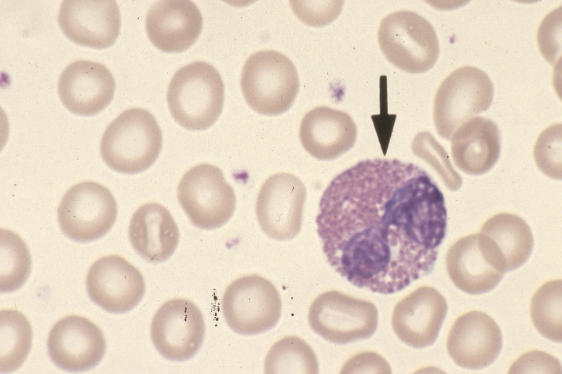
knowt flashcard image
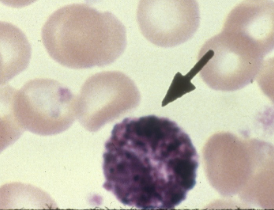
knowt flashcard image
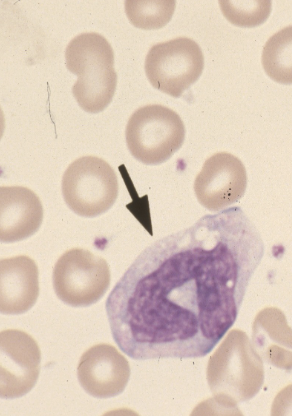
knowt flashcard image
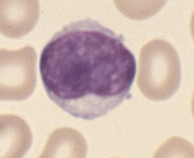
knowt flashcard image
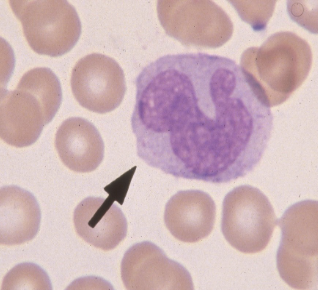
knowt flashcard image
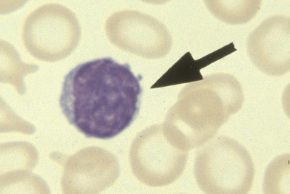
knowt flashcard image
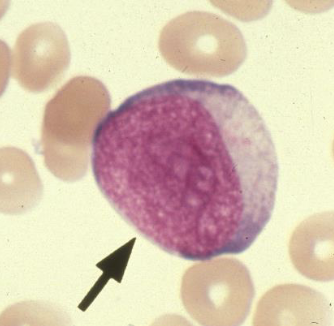
knowt flashcard image
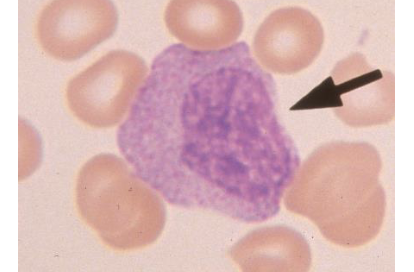
knowt flashcard image
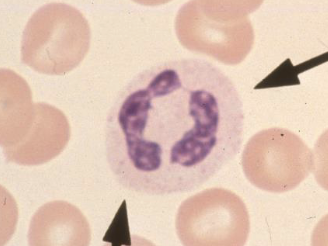
knowt flashcard image
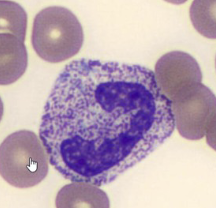
<p>variation</p>
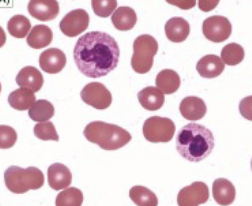
<p>variation</p>
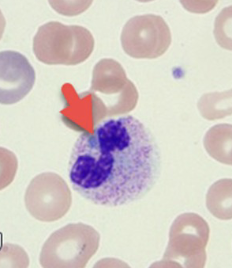
<p>variation</p>
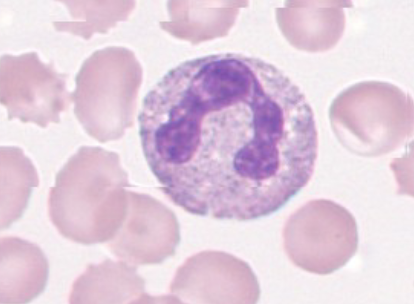
knowt flashcard image
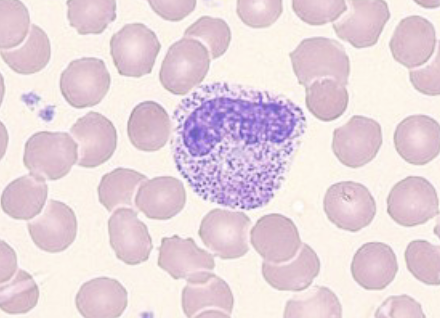
knowt flashcard image
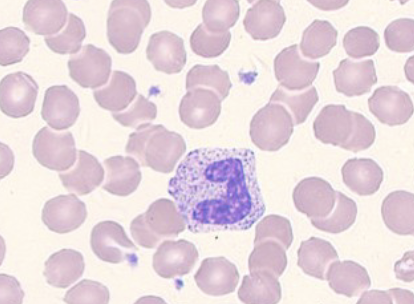
knowt flashcard image

WBCs and Precursors
0.0(0)
Card Sorting
1/34
There's no tags or description
Looks like no tags are added yet.
Last updated 1:37 AM on 11/11/25
Name | Mastery | Learn | Test | Matching | Spaced | Call with Kai |
|---|
No analytics yet
Send a link to your students to track their progress
35 Terms
1
New cards
Neutrophil
2
New cards
Neutrophil
3
New cards
Band neutrophil

4
New cards
Eosinophil
5
New cards
Basophil
6
New cards
Monocyte
7
New cards
Lymphocyte
8
New cards
Monocyte
9
New cards
Lymphocyte
10
New cards
Monocyte

11
New cards
Neutrophil

12
New cards
Blast
13
New cards
Promyelocyte

14
New cards
Myelocyte
15
New cards
Metamyelocyte

16
New cards
Band neutrophil

17
New cards
Neutrophil
18
New cards
Hypersegmentation
variation

19
New cards
toxic granulation
variation
20
New cards
Hyposegmentation
variation
21
New cards
Dohle bodies
variation
22
New cards
Vacuoles
Variation

23
New cards
Blast

24
New cards
myelocyte

25
New cards
Band
26
New cards
metamyelocyte

27
New cards
band
28
New cards
Band
29
New cards
promyelocyte

30
New cards
metamyelocyte

31
New cards
blast

32
New cards
metamyelocyte

33
New cards
myelocyte

34
New cards
blast

35
New cards